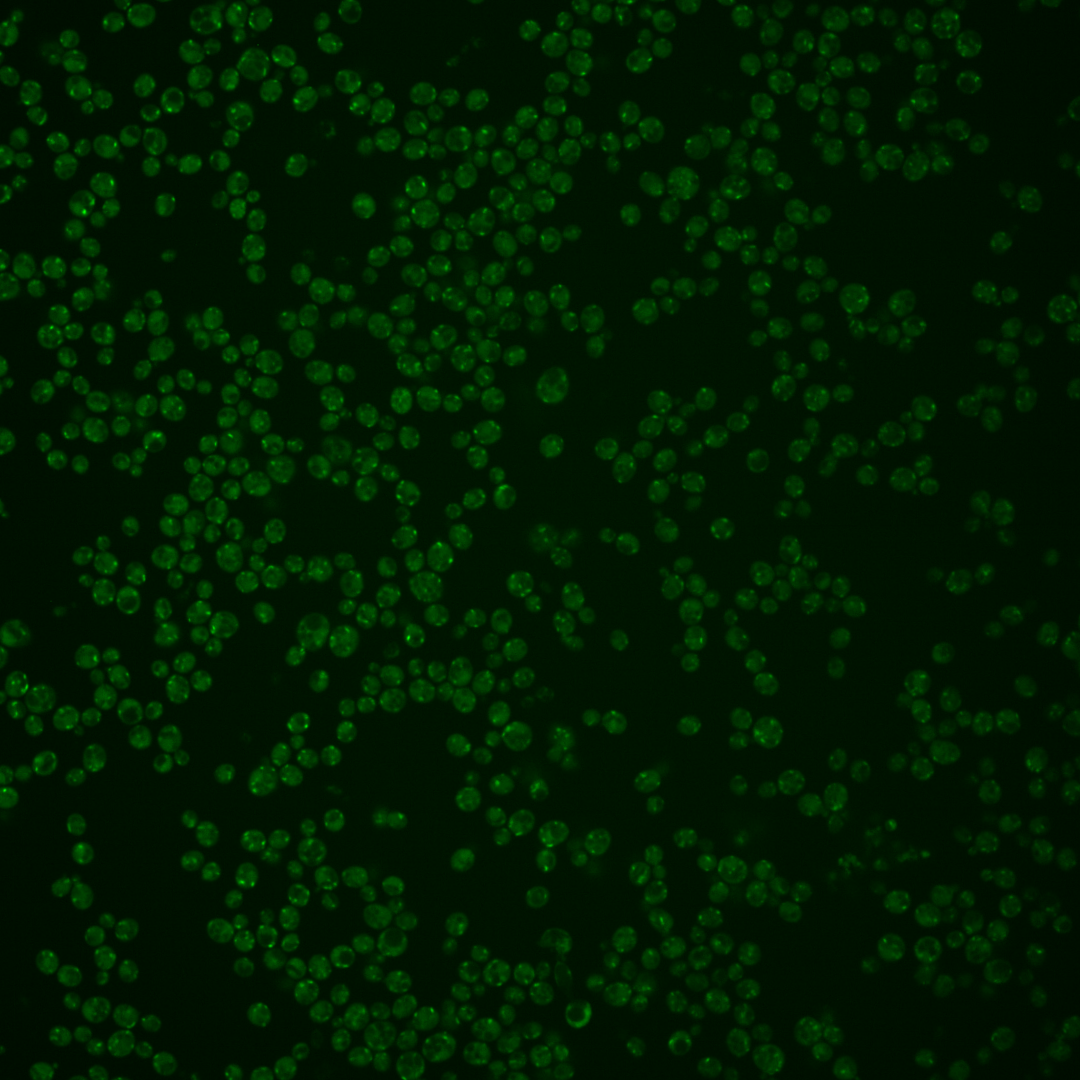
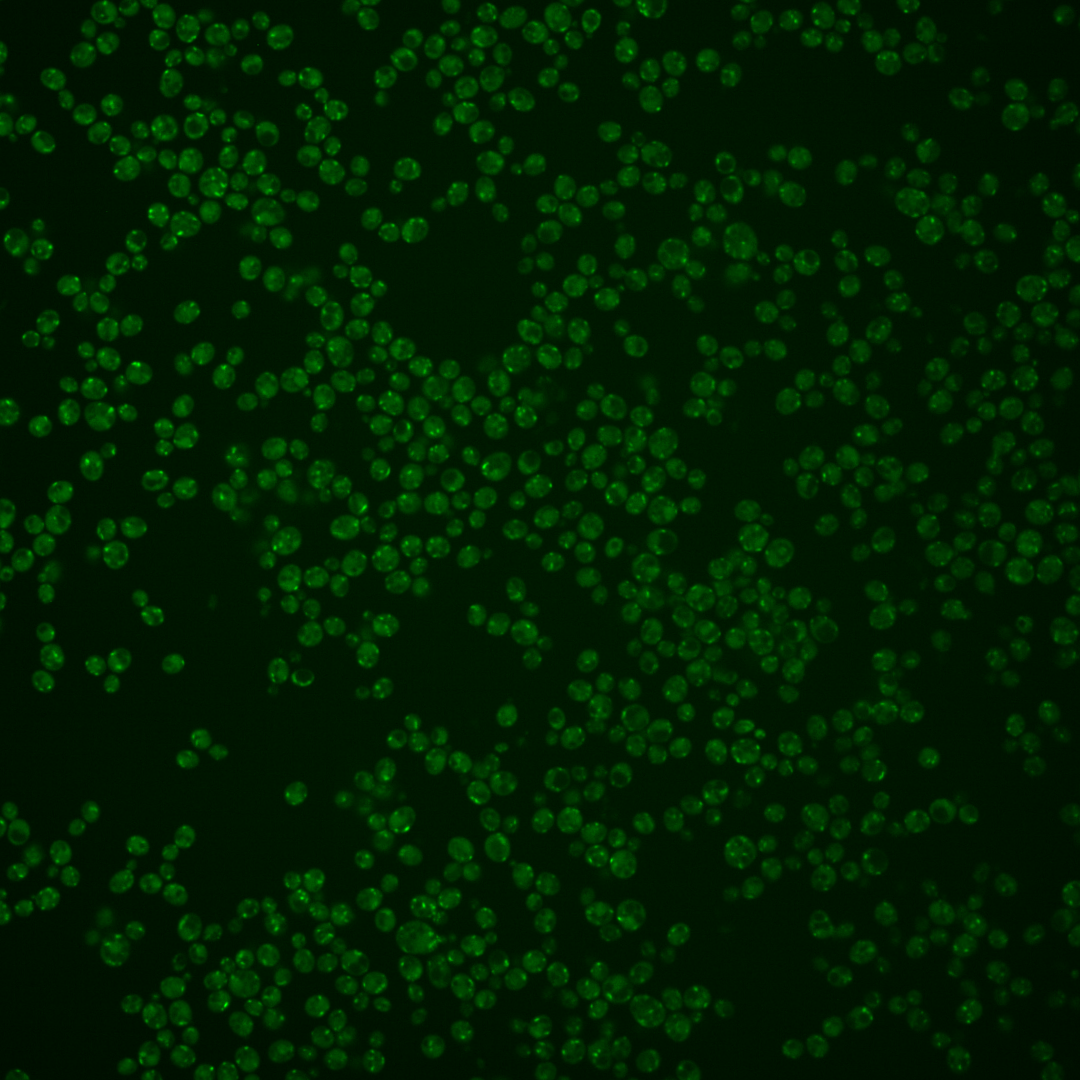

| Standard name | |
|---|---|
| Human Ortholog | |
| Description | Subunit a of the vacuolar-ATPase V0 domain; one of two isoforms (Stv1p and Vph1p); Stv1p is located in V-ATPase complexes of the Golgi and endosomes while Vph1p is located in V-ATPase complexes of the vacuole |
Micrographs




















































































Sub-cellular Localization
Yeast GFP Assignment
Protein Abundance
Localization Change
External localization resources
| ensLOC | DeepLoc | |||||||||||||||||||||||
|---|---|---|---|---|---|---|---|---|---|---|---|---|---|---|---|---|---|---|---|---|---|---|---|---|
| Localization | WT1 | WT2 | WT3 | RAP60 | RAP140 | RAP220 | RAP300 | RAP380 | RAP460 | RAP540 | RAP620 | RAP700 | HU80 | HU120 | HU160 | rpd3Δ_1 | rpd3Δ_2 | rpd3Δ_3 | WT1 | WT2 | WT3 | AF100 | AF140 | AF180 |
| Cortical Patches | 8 | 13 | 6 | 0 | 1 | 1 | 0 | 1 | – | 1 | 5 | 0 | 2 | 3 | 1 | 4 | 10 | 3 | 10 | 8 | 6 | 1 | 4 | 5 |
| Bud | 9 | 3 | 10 | 12 | 9 | 9 | 24 | 23 | – | 20 | 19 | 25 | 0 | 0 | 0 | 4 | 0 | 3 | 2 | 0 | 0 | 0 | 0 | 0 |
| Bud Neck | 0 | 0 | 0 | 0 | 0 | 0 | 0 | 0 | – | 0 | 0 | 0 | 0 | 0 | 0 | 1 | 0 | 0 | 0 | 0 | 0 | 0 | 0 | 0 |
| Bud Site | 0 | 0 | 2 | 0 | 0 | 2 | 3 | 1 | – | 4 | 3 | 5 | 0 | 0 | 0 | 0 | 0 | 0 | – | – | – | – | – | – |
| Cell Periphery | 1 | 0 | 0 | 0 | 0 | 0 | 0 | 0 | – | 1 | 3 | 0 | 0 | 0 | 0 | 0 | 0 | 0 | 0 | 0 | 0 | 0 | 0 | 0 |
| Cytoplasm | 33 | 12 | 23 | 22 | 33 | 32 | 32 | 26 | – | 22 | 14 | 17 | 2 | 3 | 13 | 62 | 21 | 17 | 3 | 1 | 3 | 0 | 1 | 0 |
| Endoplasmic Reticulum | 10 | 9 | 3 | 0 | 1 | 3 | 3 | 1 | – | 5 | 1 | 5 | 0 | 1 | 4 | 16 | 2 | 2 | 0 | 0 | 2 | 0 | 2 | 0 |
| Endosome | 128 | 5 | 109 | 72 | 76 | 10 | 7 | 26 | – | 4 | 4 | 10 | 2 | 3 | 33 | 87 | 13 | 17 | 152 | 47 | 115 | 14 | 42 | 44 |
| Golgi | 23 | 8 | 13 | 12 | 10 | 1 | 0 | 0 | – | 1 | 3 | 0 | 0 | 4 | 21 | 4 | 3 | 4 | 138 | 34 | 91 | 13 | 40 | 48 |
| Mitochondria | 178 | 116 | 83 | 113 | 95 | 240 | 270 | 222 | – | 268 | 227 | 306 | 13 | 15 | 26 | 30 | 5 | 8 | 69 | 36 | 25 | 10 | 25 | 25 |
| Nucleus | 2 | 0 | 0 | 0 | 1 | 3 | 1 | 2 | – | 0 | 2 | 0 | 1 | 0 | 0 | 0 | 2 | 3 | 0 | 0 | 0 | 0 | 0 | 0 |
| Nuclear Periphery | 0 | 3 | 1 | 0 | 0 | 0 | 0 | 0 | – | 2 | 2 | 1 | 0 | 0 | 0 | 1 | 1 | 0 | 0 | 0 | 1 | 0 | 0 | 0 |
| Nucleolus | 2 | 0 | 0 | 1 | 3 | 6 | 6 | 7 | – | 6 | 4 | 2 | 3 | 0 | 2 | 0 | 0 | 0 | 0 | 0 | 0 | 0 | 0 | 0 |
| Peroxisomes | 29 | 0 | 45 | 16 | 10 | 6 | 26 | 9 | – | 7 | 6 | 2 | 0 | 2 | 4 | 11 | 0 | 0 | 50 | 15 | 62 | 10 | 12 | 12 |
| SpindlePole | 36 | 6 | 51 | 14 | 14 | 11 | 24 | 28 | – | 11 | 11 | 10 | 2 | 0 | 7 | 56 | 8 | 10 | 14 | 3 | 3 | 0 | 1 | 1 |
| Vac/Vac Membrane | 31 | 5 | 7 | 15 | 16 | 11 | 12 | 6 | – | 7 | 12 | 15 | 0 | 1 | 6 | 35 | 7 | 4 | 14 | 4 | 3 | 0 | 5 | 7 |
| Unique Cell Count | 361 | 139 | 252 | 204 | 214 | 279 | 328 | 280 | 297 | 257 | 336 | 18 | 26 | 94 | 243 | 59 | 51 | 464 | 155 | 322 | 55 | 139 | 151 | |
| Labelled Cell Count | 490 | 180 | 353 | 277 | 269 | 335 | 408 | 352 | 359 | 316 | 398 | 25 | 32 | 117 | 311 | 72 | 71 | 464 | 155 | 322 | 55 | 139 | 151 | |
Yeast GFP Assignment
Protein Abundance
| Screen | WT1 | WT2 | WT3 | RAP60 | RAP140 | RAP220 | RAP300 | RAP380 | RAP460 | RAP540 | RAP620 | RAP700 | HU80 | HU120 | HU160 | rpd3Δ_1 | rpd3Δ_2 | rpd3Δ_3 | AF100 | AF140 | AF180 |
|---|---|---|---|---|---|---|---|---|---|---|---|---|---|---|---|---|---|---|---|---|---|
| Mean Cell GFP Intensity (1e-4) | 5.8 | 5.3 | 5.9 | 5.8 | 5.6 | 4.9 | 4.6 | 4.9 | – | 4.4 | 4.7 | 4.7 | 6.2 | 6.7 | 7.3 | 5.5 | 6.2 | 6.6 | 5.6 | 7.4 | 8.0 |
| Std Deviation (1e-4) | 0.8 | 0.7 | 1.6 | 1.4 | 1.6 | 1.5 | 1.3 | 1.5 | – | 1.0 | 1.0 | 1.0 | 1.0 | 1.0 | 1.4 | 1.1 | 1.1 | 1.1 | 0.7 | 2.0 | 2.5 |
| Intensity Change (Log2) | – | – | – | -0.03 | -0.06 | -0.26 | -0.37 | -0.26 | – | -0.41 | -0.32 | -0.32 | 0.09 | 0.19 | 0.31 | -0.1 | 0.07 | 0.15 | -0.06 | 0.33 | 0.45 |
Localization Change
| Localization | RAP60 | RAP140 | RAP220 | RAP300 | RAP380 | RAP460 | RAP540 | RAP620 | RAP700 | HU80 | HU120 | HU160 | rpd3Δ_1 | rpd3Δ_2 | rpd3Δ_3 |
|---|---|---|---|---|---|---|---|---|---|---|---|---|---|---|---|
| Cortical Patches | 0 | 0 | 0 | 0 | 0 | – | 0 | 0 | 0 | 0 | 0 | 0 | 0 | 0 | 0 |
| Bud | 0.9 | 0.1 | -0.5 | 0 | 2.0 | – | 0 | 0 | 0 | 0 | 0 | 0 | -1.6 | 0 | 0 |
| Bud Neck | 0 | 0 | 0 | 0 | 0 | – | 0 | 0 | 0 | 0 | 0 | 0 | 0 | 0 | 0 |
| Bud Site | 0 | 0 | 0 | 0 | 0 | – | 0 | 0 | 0 | 0 | 0 | 0 | 0 | 0 | 0 |
| Cell Periphery | 0 | 0 | 0 | 0 | 0 | – | 0 | 0 | 0 | 0 | 0 | 0 | 0 | 0 | 0 |
| Cytoplasm | 0.6 | 2.1 | 0.9 | 0.3 | 0.1 | – | -0.7 | -1.6 | -1.9 | 0 | 0 | 1.3 | 4.8 | 5.3 | 4.7 |
| Endoplasmic Reticulum | 0 | 0 | 0 | 0 | 0 | – | 0 | 0 | 0 | 0 | 0 | 0 | 3.1 | 0 | 0 |
| Endosome | -1.7 | -1.7 | -10.9 | 0 | -9.0 | – | 0 | 0 | 0 | -2.7 | -3.1 | -1.4 | -1.7 | -3.0 | -1.3 |
| Golgi | 0.3 | -0.2 | -3.4 | 0 | -3.8 | – | 0 | 0 | 0 | 0 | 0 | 4.8 | -2.1 | 0 | 0 |
| Mitochondria | 4.8 | 2.5 | 12.5 | 0 | 10.8 | – | 0 | 0 | 0 | 3.4 | 2.5 | -0.9 | -5.5 | -3.8 | -2.5 |
| Nucleus | 0 | 0 | 0 | 0 | 0 | – | 0 | 0 | 0 | 0 | 0 | 0 | 0 | 0 | 0 |
| Nuclear Periphery | 0 | 0 | 0 | 0 | 0 | – | 0 | 0 | 0 | 0 | 0 | 0 | 0 | 0 | 0 |
| Nucleolus | 0 | 0 | 0 | 0 | 0 | – | 0 | 0 | 0 | 0 | 0 | 0 | 0 | 0 | 0 |
| Peroxisomes | -3.1 | -4.4 | -6.1 | 0 | -5.6 | – | 0 | 0 | 0 | 0 | 0 | -3.2 | -4.7 | -3.5 | -3.3 |
| SpindlePole | -4.1 | -4.3 | -5.8 | 0 | -3.3 | – | 0 | 0 | 0 | 0 | 0 | -2.8 | 0.8 | -1.2 | -0.1 |
| Vacuole | 2.3 | 2.3 | 0.7 | 0.6 | -0.5 | – | -0.3 | 1.1 | 1.1 | 0 | 0 | 0 | 4.6 | 0 | 0 |
External localization resources
Images






























Protein Concentration and Protein Localization Data
| R1 | R2 | R3 | ||||||||||||||||
|---|---|---|---|---|---|---|---|---|---|---|---|---|---|---|---|---|---|---|
| G1 Pre-START | G1 Post-START | S/G2 | Metaphase | Anaphase | Telophase | G1 Pre-START | G1 Post-START | S/G2 | Metaphase | Anaphase | Telophase | G1 Pre-START | G1 Post-START | S/G2 | Metaphase | Anaphase | Telophase | |
| Concentration | 2.3645 | 3.6255 | 3.5357 | 3.329 | 3.4021 | 3.6158 | 5.5265 | 6.7186 | 5.9873 | 5.9109 | 5.1468 | 5.8066 | 5.7698 | 7.0478 | 6.3973 | 7.0864 | 6.8103 | 6.643 |
| Actin | 0.0031 | 0.011 | 0.0114 | 0.0017 | 0.0065 | 0.0179 | 0.0283 | 0.0175 | 0.0134 | 0.001 | 0.031 | 0.0262 | 0.0054 | 0.0116 | 0.0099 | 0.0015 | 0.0022 | 0.0073 |
| Bud | 0.0003 | 0.0013 | 0.0002 | 0.0003 | 0.0001 | 0.0003 | 0.0002 | 0.0003 | 0.0004 | 0 | 0.0011 | 0.0002 | 0.0001 | 0.0003 | 0.0002 | 0.0002 | 0.0001 | 0.0002 |
| Bud Neck | 0.0003 | 0.0007 | 0.0064 | 0.0003 | 0.0004 | 0.0012 | 0.0004 | 0.0003 | 0.0008 | 0.0002 | 0.0003 | 0.0008 | 0.0002 | 0.0003 | 0.0005 | 0.0037 | 0.0002 | 0.0003 |
| Bud Periphery | 0.0002 | 0.0009 | 0.0002 | 0.0003 | 0.0001 | 0.0003 | 0.0002 | 0.0002 | 0.0004 | 0 | 0.0011 | 0.0003 | 0.0001 | 0.0006 | 0.0003 | 0.0002 | 0.0001 | 0.0002 |
| Bud Site | 0.0003 | 0.0052 | 0.0015 | 0.0007 | 0.0004 | 0.0007 | 0.0007 | 0.001 | 0.0025 | 0.0001 | 0.0027 | 0.0004 | 0.0002 | 0.0012 | 0.0013 | 0.0003 | 0.0001 | 0.0001 |
| Cell Periphery | 0.0001 | 0.0002 | 0.0001 | 0 | 0 | 0.0001 | 0.0001 | 0.0001 | 0.0001 | 0 | 0.0001 | 0.0001 | 0.0001 | 0 | 0.0001 | 0 | 0 | 0 |
| Cytoplasm | 0.0083 | 0.0139 | 0.0025 | 0.0018 | 0.0019 | 0.0034 | 0.0092 | 0.0024 | 0.0063 | 0.0005 | 0.0056 | 0.0025 | 0.0029 | 0.0025 | 0.0022 | 0.001 | 0.0042 | 0.0018 |
| Cytoplasmic Foci | 0.1684 | 0.2193 | 0.1863 | 0.162 | 0.1546 | 0.1379 | 0.1427 | 0.1908 | 0.1848 | 0.1022 | 0.1334 | 0.1404 | 0.1823 | 0.2052 | 0.1775 | 0.2166 | 0.2055 | 0.1633 |
| Eisosomes | 0.0001 | 0.0001 | 0.0001 | 0 | 0 | 0.0001 | 0.0001 | 0 | 0.0001 | 0 | 0.0001 | 0.0001 | 0.0001 | 0 | 0 | 0 | 0 | 0 |
| Endoplasmic Reticulum | 0.0018 | 0.0014 | 0.0002 | 0.0003 | 0.0006 | 0.0008 | 0.0012 | 0.0008 | 0.0019 | 0.0001 | 0.0005 | 0.0006 | 0.0004 | 0.0007 | 0.0003 | 0.0001 | 0.0005 | 0.0002 |
| Endosome | 0.2376 | 0.2349 | 0.2303 | 0.2569 | 0.2908 | 0.1971 | 0.2562 | 0.2082 | 0.2718 | 0.2443 | 0.1575 | 0.1898 | 0.2469 | 0.236 | 0.2169 | 0.2247 | 0.2759 | 0.168 |
| Golgi | 0.2909 | 0.3349 | 0.3775 | 0.4457 | 0.3894 | 0.4097 | 0.2754 | 0.3919 | 0.282 | 0.305 | 0.2137 | 0.3759 | 0.3512 | 0.3877 | 0.383 | 0.4335 | 0.3628 | 0.4232 |
| Lipid Particles | 0.1064 | 0.0429 | 0.0401 | 0.0369 | 0.0253 | 0.0541 | 0.109 | 0.0451 | 0.0572 | 0.1532 | 0.1501 | 0.0986 | 0.0682 | 0.0274 | 0.0444 | 0.0121 | 0.0441 | 0.0553 |
| Mitochondria | 0.0175 | 0.0275 | 0.0158 | 0.0355 | 0.0153 | 0.0362 | 0.0161 | 0.0214 | 0.0304 | 0.0072 | 0.0147 | 0.0396 | 0.0174 | 0.007 | 0.0196 | 0.0071 | 0.0064 | 0.0187 |
| None | 0.0077 | 0.0026 | 0.0012 | 0.0001 | 0.0001 | 0.0027 | 0.0027 | 0.0004 | 0.0074 | 0 | 0.0866 | 0.007 | 0.0019 | 0.0038 | 0.0011 | 0.0001 | 0.0058 | 0.0002 |
| Nuclear Periphery | 0.0038 | 0.0006 | 0.0001 | 0.0001 | 0.0001 | 0.0009 | 0.0046 | 0.0008 | 0.0008 | 0.0001 | 0.0006 | 0.0003 | 0.0001 | 0.0003 | 0.0002 | 0 | 0.0002 | 0.0001 |
| Nucleolus | 0.0054 | 0.0015 | 0.0001 | 0.0001 | 0 | 0.0001 | 0.0003 | 0.0001 | 0.0001 | 0 | 0.0001 | 0.0001 | 0.0001 | 0.0002 | 0.0001 | 0 | 0 | 0 |
| Nucleus | 0.0039 | 0.0005 | 0.0001 | 0.0001 | 0 | 0.0003 | 0.0018 | 0.0001 | 0.0001 | 0 | 0.0001 | 0.0001 | 0 | 0.0002 | 0.0001 | 0 | 0 | 0 |
| Peroxisomes | 0.139 | 0.093 | 0.1237 | 0.0527 | 0.1111 | 0.1327 | 0.1365 | 0.1148 | 0.1346 | 0.1831 | 0.1969 | 0.1125 | 0.1199 | 0.1118 | 0.14 | 0.097 | 0.0899 | 0.1593 |
| Punctate Nuclear | 0.0017 | 0.0025 | 0.0006 | 0.0017 | 0.0002 | 0.0007 | 0.0108 | 0.0016 | 0.0008 | 0.0002 | 0.0015 | 0.0012 | 0.0004 | 0.0006 | 0.0005 | 0.0003 | 0.0003 | 0.0002 |
| Vacuole | 0.0018 | 0.0034 | 0.001 | 0.0014 | 0.0014 | 0.0016 | 0.002 | 0.0011 | 0.0021 | 0.0014 | 0.0012 | 0.0014 | 0.0012 | 0.0017 | 0.001 | 0.0009 | 0.0009 | 0.0006 |
| Vacuole Periphery | 0.0015 | 0.0017 | 0.0009 | 0.0015 | 0.0016 | 0.0014 | 0.0017 | 0.0011 | 0.002 | 0.0013 | 0.0011 | 0.0019 | 0.001 | 0.001 | 0.0009 | 0.0006 | 0.0008 | 0.0008 |
Sequencing Data
| R1 | R2 | |||||||||
|---|---|---|---|---|---|---|---|---|---|---|
| G1 Post-START | S/G2 | Metaphase | Anaphase | Telophase | G1 Post-START | S/G2 | Metaphase | Anaphase | Telophase | |
| Gene Expression | 22.7038 | 35.0564 | 28.4778 | 37.5682 | 23.014 | 24.3415 | 51.7691 | 53.2608 | 48.2422 | 46.3067 |
| Translational Efficiency | 1.0222 | 1.0496 | 0.953 | 0.7417 | 0.8647 | 1.1418 | 0.7721 | 0.5826 | 0.601 | 0.5678 |
Hit Data
| Dataset | Hit |
|---|---|
| Protein Concentration | ✔ |
| Protein Localization | ✘ |
| Gene Expression | ✔ |
| Translational Efficiency | ✘ |
Endocytosis
| Temp | Actin Patch (Sac6-tdTomato) | Cortical Patch (Sla1-GFP) | Late Endosome (Snf7-GFP) | Vacuole (Vph1-GFP) |
|---|---|---|---|---|
| 37℃ | ||||
| RT |
Cell Cycle Omics
CYCLoPs (Stv1-GFP)
| Gene / Allele | Actin Patch (Sac6-tdTomato) | Cortical Patch (Sla1-GFP) | Late Endosome (Snf7-GFP) | Vacuole (Sac6-tdTomato) |
|---|
| Gene | Images |
|---|
| Gene | Images |
|---|
Images are not yet available
Images are not yet available